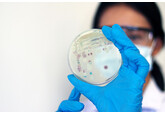
Ученые выяснили, какой грибок переживет путешествие на Марс

Мозг каждого человека «настроен» на музыку с рождения, выяснили ученые
CurBio: способностью к восприятию музыки проявляется в первые дни жизни
Ученые из Амстердамского университета пришли к выводу, что способность воспринимать музыку заложена в человеке биологически и проявляется уже в первые дни жизни. Работа опубликована в журнале Current Biology (CurBio).
Работа показала: новорожденные реагируют на ритм и мелодию задолго до того, как начинают говорить, учиться или взаимодействовать с культурой. Это означает, что музыкальность нельзя считать исключительно приобретенным навыком — она является частью врожденных свойств мозга.
По данным исследования, младенцы с раннего возраста способны распознавать ритмические структуры и группировать звуки по высоте. Эти базовые механизмы формируют фундамент для дальнейшего восприятия музыки. При этом культура влияет уже позже — определяя стили, инструменты и музыкальные традиции.
Ученые отмечают, что музыкальность — это не одна способность, а целый комплекс функций. В него входят чувство ритма, запоминание звуковых паттернов, эмоциональная реакция и предсказание структуры мелодии. Эти процессы задействуют разные участки мозга и могут иметь различное эволюционное происхождение.
Дополнительные подтверждения получены в исследованиях на животных.
«Например, макаки и некоторые виды птиц также демонстрируют способность синхронизироваться с ритмом. Это указывает на древние биологические механизмы, лежащие в основе музыкального восприятия», — отметили исследователи.
Отдельно подчеркивается, что музыка и речь обрабатываются мозгом по-разному. Люди с врожденной амузией могут нормально осваивать язык, но испытывают трудности с музыкальными структурами, что подтверждает независимость этих систем.
Авторы считают, что музыка возникла не как отдельная функция, а как результат объединения более древних механизмов — восприятия звука, движения и эмоций. Это объясняет, почему музыка одновременно влияет на память, настроение и моторные процессы.
По мнению исследователей, понимание врожденной музыкальности может расширить применение музыкальной терапии — например, в восстановлении речи, координации движений и эмоционального состояния.
CurBio